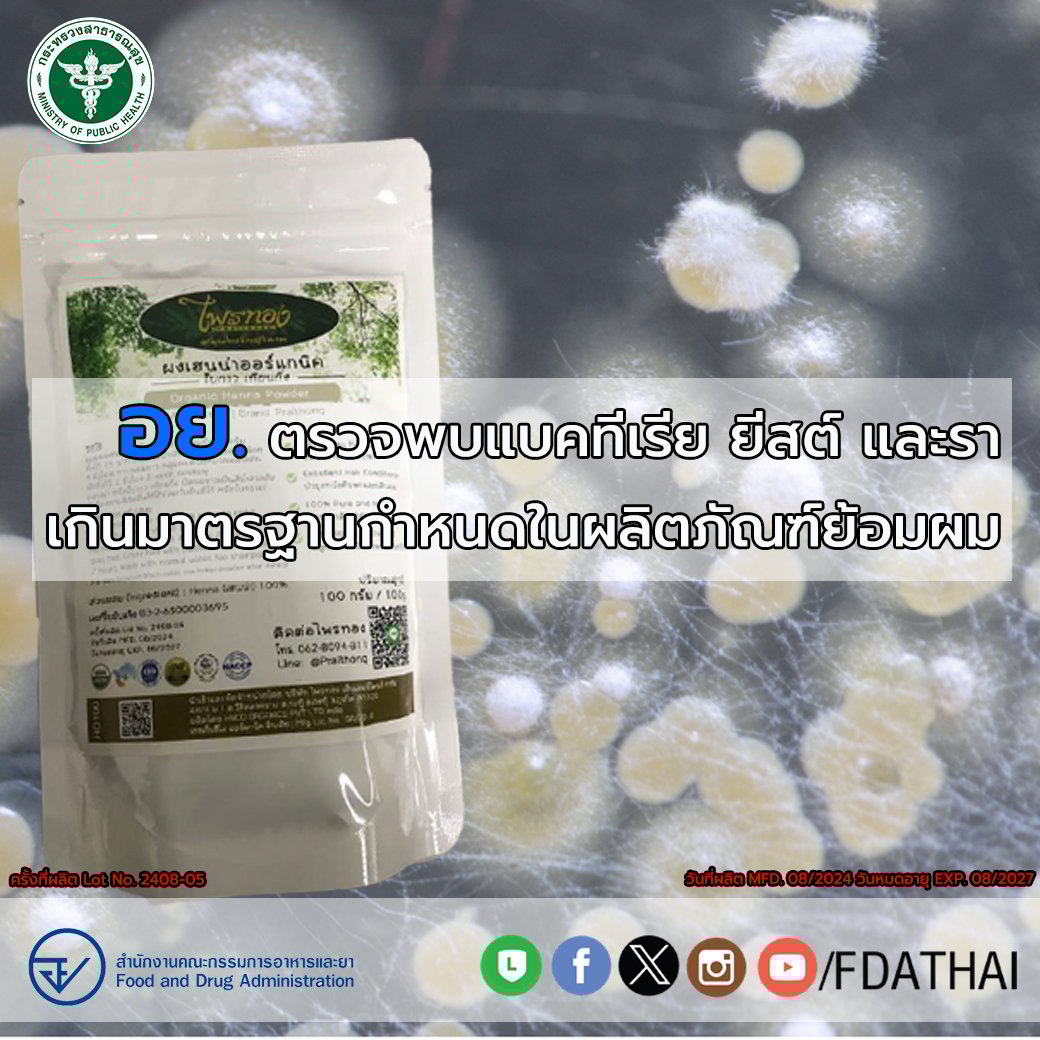

อย.เตือน ‘ยาย้อมผมออร์แกนิค’ ยี่ห้อดัง ตรวจเจอแบคทีเรีย-รา เกินมาตรฐาน 19 เท่า

อย. ประกาศเตือน ยาย้อมผมออร์แกนิค ยี่ห้อดัง หลังตรวจพบเชื้อแบคทีเรีย ยีสต์ และรา เกินมาตรฐานถึง 19 เท่า แนะประชาชนหยุดใช้ทันที
เมื่อวันที่ 2 กันยายน 2568 สำนักงานคณะกรรมการอาหารและยา (อย.) ได้เผยแพร่ผลการตรวจสอบและวิเคราะห์เครื่องสำอางให้ประชาชนได้รับรู้โดยทั่วกัน ซึ่งในครั้งนี้ ยาย้อมผมออแกนิค ยี่ห้อดังถูกตรวจพบ แบคทีเรีย-ยีสต์-รา เกินมาตรฐาน เป็นอันตรายต่อผู้ใช้เป็นอย่างมาก
สำนักงานคณะกรรมการอาหารและยา ได้เก็บตัวอย่างเครื่องสำอางจากด่านอาหารและยาท่าเรือกรุงเทพ โดยได้เก็บตัวอย่างเครื่องสำอาง ไพรทอง ผงเฮนน่าออร์แกนิค (PRAITHONG ORGANIC HENNA POWDER) ครั้งที่ผลิต Lot No. 2408-05 วันที่ผลิต MFD. 08/2024 วันหมดอายุ EXP. 08/2027 เมื่อวันที่ 18 ตุลาคม 2567 ส่งตรวจวิเคราะห์ที่กรมวิทยาศาสตร์การแพทย์ พบจำนวนรวมของแบคทีเรีย ยีสต์ และรา ที่เจริญเติบโตโดยใช้อากาศ (Total aerobic plate count) เกินมาตรฐานกำหนด จัดเป็นเครื่องสำอางที่มีลักษณะตามประกาศกระทรวงสาธารณสุข เรื่อง กำหนดลักษณะของเครื่องสำอางที่ห้ามผลิต นำเข้า หรือขาย พ.ศ. 2559 จึงขอประกาศผลการตรวจสอบหรือผลวิเคราะห์เครื่องสำอางให้ประชาชนทราบ ดังนี้
ผลตรวจวิเคราะห์เครื่องสำอางดังกล่าว ตรวจพบเชื้อจุลินทรีย์ซึ่งอาจจะก่อให้เกิดอันตรายแก่ผู้บริโภคได้ คือ ตรวจพบจำนวนรวมของแบคทีเรีย ยีสต์ และรา ที่เจริญเติบโตโดยใช้อากาศ (Total aerobic plate count) 19,000 โคโลนีต่อกรัม ซึ่งมากกว่า 1,000 โคโลนีต่อกรัม
ข้อแนะนำ
ขอให้เลือกซื้อเครื่องสำอางด้วยความระมัดระวัง ทั้งนี้ ประชาชนควรเลือกซื้อเครื่องสำอางจากร้านค้าที่มีหลักแหล่งแน่นอน ฉลากภาษาไทยมีข้อความตามที่กฎหมายกำหนดอย่างครบถ้วน ได้แก่ ชื่อเครื่องสำอาง ชื่อทางการค้า ประเภทเครื่องสำอาง ชื่อของสารที่ใช้เป็นส่วนผสม วิธีใช้ ชื่อและที่ตั้งของผู้ผลิต ผู้นำเข้า ปริมาณสุทธิ ครั้งที่ผลิต เดือนปีที่ผลิตหรือปีเดือนที่ผลิต คำเตือน (ถ้ามี) และเลขที่ใบรับจดแจ้ง สำหรับร้านค้าที่ซื้อเครื่องสำอางเพื่อจำหน่าย ควรซื้อจากผู้มีหลักแหล่งน่าเชื่อถือ และมีหลักฐานการซื้อขายที่ระบุชื่อและที่ตั้งของผู้ขายอย่างชัดเจน
กรณีที่พบผลิตภัณฑ์ ที่สงสัยว่าจะเป็นอันตราย สามารถสอบถามหรือร้องเรียนได้ที่ สายด่วน อย. 1556 หรือผ่าน Line @FDAThai, Facebook: FDAThai หรือ E-mail: 1556@fda.moph.go.th ตู้ปณ. 1556 ปณฝ. กระทรวงสาธารณสุข จ.นนทบุรี 11004 หรือสำนักงานสาธารณสุขจังหวัดทั่วประเทศ

อ่านข่าวที่เกี่ยวข้อง
- อย. เตือน ยาย้อมผมยี่ห้อดัง เจอเชื้อรา-แบคทีเรีย เกินมาตรฐาน 500 เท่า
- แพทย์เตือน ย้อมปิดผมหงอก-ทำสีผมบ่อย เสี่ยงโรคตับ-ไตพัง
- สยอง นักกีฬาอายุ 16 ทำสีผม ได้แผลเหวอะ ต้องให้แพทย์ผ่าตัด
- สุดสยอง! สาวมะกัน ฟอกสีผม สุดท้ายหนังหัวไหม้เป็นรู ซ้ำเก็บเงิน-ไร้คำขอโทษ
อ้างอิงจาก : FB FDA Thai, oryor
ติดตาม The Thaiger บน Google News:





